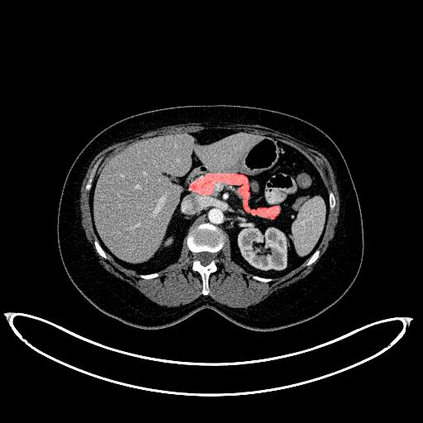
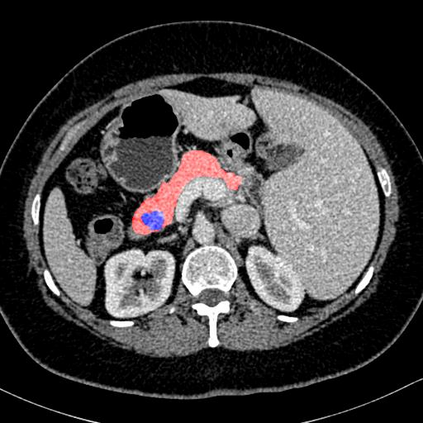
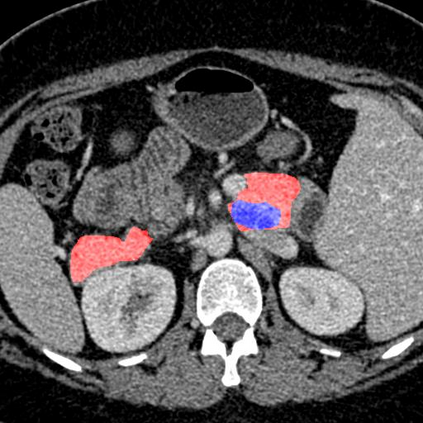

In this paper, we adopt 3D Convolutional Neural Networks to segment volumetric medical images. Although deep neural networks have been proven to be very effective on many 2D vision tasks, it is still challenging to apply them to 3D tasks due to the limited amount of annotated 3D data and limited computational resources. We propose a novel 3D-based coarse-to-fine framework to effectively and efficiently tackle these challenges. The proposed 3D-based framework outperforms the 2D counterpart to a large margin since it can leverage the rich spatial infor- mation along all three axes. We conduct experiments on two datasets which include healthy and pathological pancreases respectively, and achieve the current state-of-the-art in terms of Dice-S{\o}rensen Coefficient (DSC). On the NIH pancreas segmentation dataset, we outperform the previous best by an average of over 2%, and the worst case is improved by 7% to reach almost 70%, which indicates the reliability of our framework in clinical applications.
翻译:在本文中,我们采用3D进化神经网络来分解体积医学图像。虽然深神经网络已证明在很多2D视觉任务方面非常有效,但由于附加说明的3D数据数量有限和计算资源有限,将它们应用到3D任务中仍具有挑战性。我们提出了一个基于3D的新颖的3D粗皮到软框架,以有效、高效地应对这些挑战。拟议的3D框架比2D对应方高出很大幅度,因为它能够利用所有三个轴的丰富空间用于 mation。我们分别对健康、病理的全心全意这两个数据集进行了实验,并实现了目前的Dice-S-S-o}rensen Covalent(DSC)最新数据。在NIH 板块分割数据集中,我们比前一个最佳的高出了2%以上,而最差的情况是7%,达到近70%,这表明了临床应用框架的可靠性。